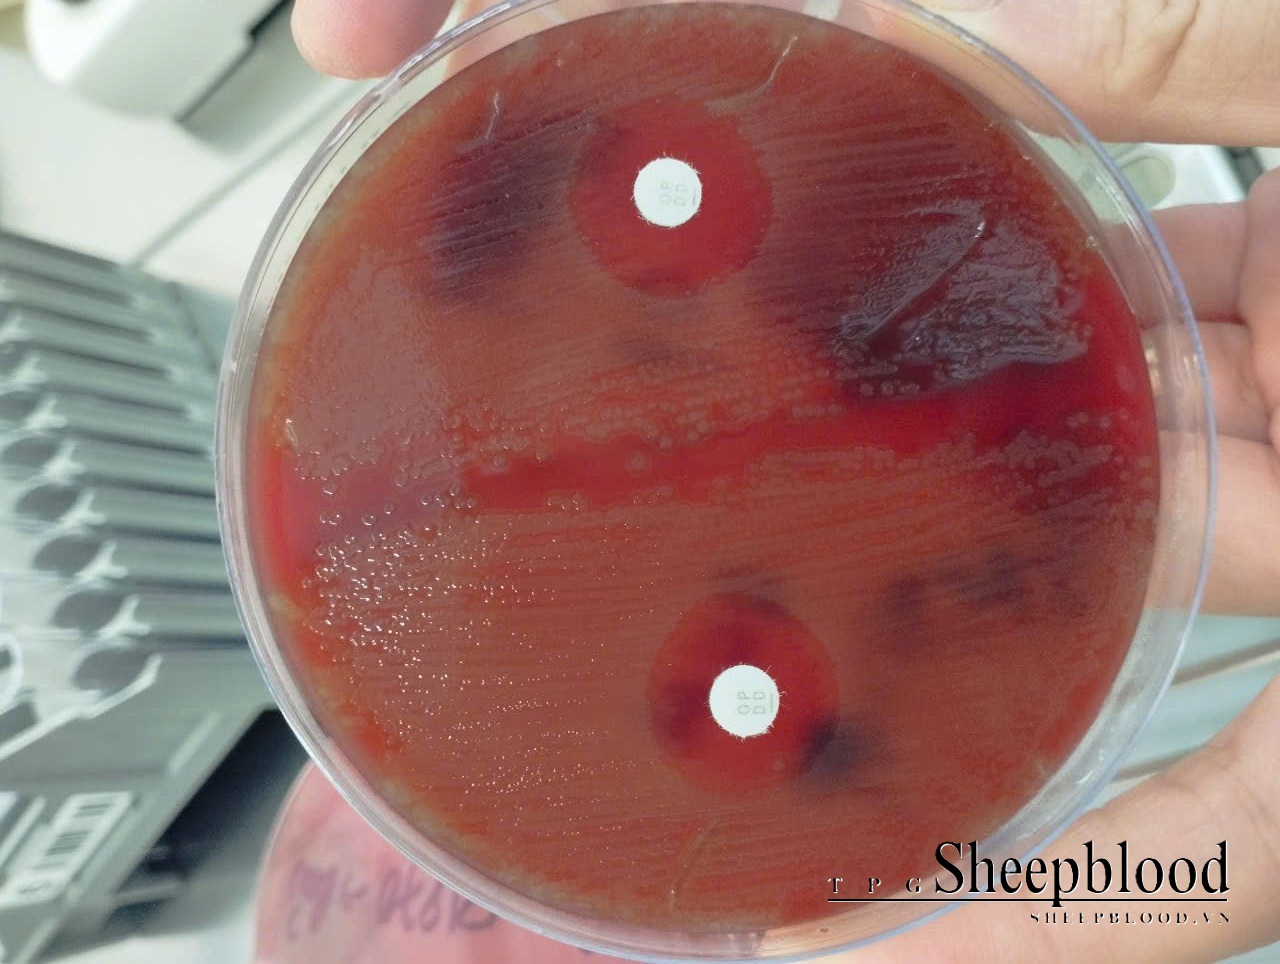
alt
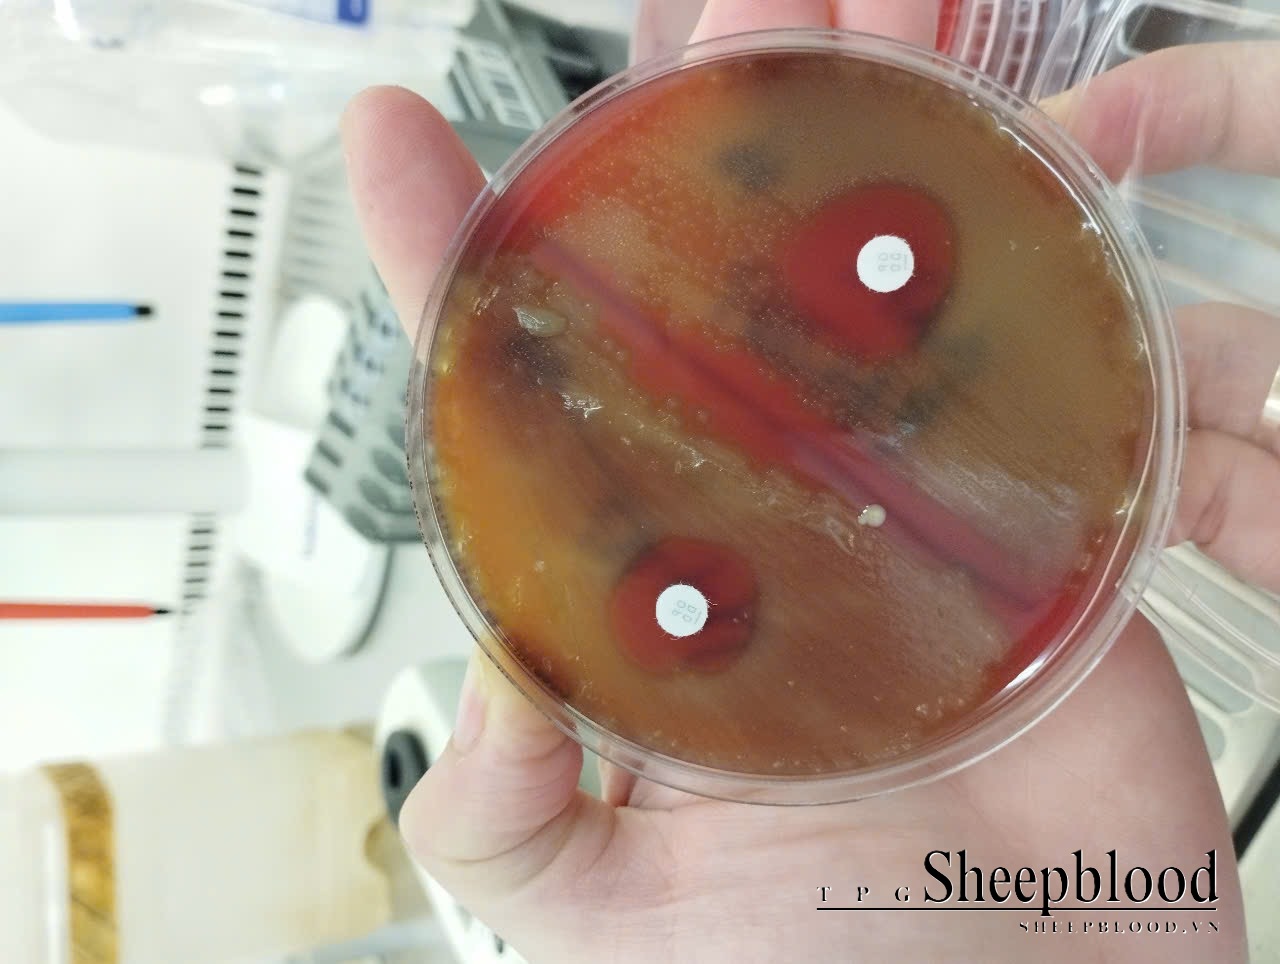
alt

Đang tải...
Đang tải...
Mueller Hinton Agar + 5% Sheep Blood với thành phần dinh dưỡng bao gồm: beef extract và acid hydrolysate của casein cung cấp amino acid, các hợp chất chưa ni tơ, vitamin, muối khoáng cần thiết cho phát triển của vi sinh vật
Columbia Agar +5% Sheep Blood là môi trường nuôi cấy phổ rộng được đề xuất sử dụng để nuôi cấy, phân lập hầu hết các loại vi sinh vật, đáp ứng yêu cầu dinh dưỡng nhằm có thể nâng cao hiệu năng thu được khuẩn lạc các vi sinh vật tối đa mà không ảnh hưởng tới phản hứng heamolytic (tan máu) của chúng.
Môi trường được xây dựng để tương thích với máu cừu và hoàn thiện hơn cho phản ứng tan máu. Special peptone và starch cung cấp nguồn nitrogen, carbon, các amino acid và các vitamin. Sodium chloride nhằm duy trì cân bằng thẩm thấu. Phản ứng tan máu là hiện tượng exotoxin mà vi khuẩn tiết ra làm phân hủy các tế bào hồng cầu .
Ở trên bề mặt đĩa thạch, các khuẩn lạc có vòng phân giải không màu gọi là kiểu tan máu bê ta. Một kiểu khác là vi khuẩn có thể làm phân hủy haemoglobin thành methaemoglobin và tạo một vùng màu xanh mờ xung quanh khuẩn lạc, kiểu này gọi là tan máu alpha. Kiểu tan máu gamma heamolysis là không có hiện tượng tan máu trên bề mặt.
Liên hệ đặt hàng:
Sdt: 0938 2345 04